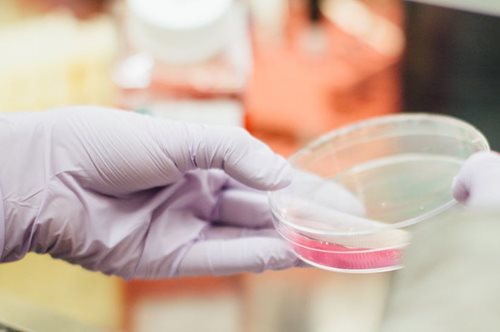
Νέα εξέταση αίματος θα ανιχνεύει τον καρκίνο του μαστού έως και πέντε χρόνια πριν από τα συμπτώματα

Νέα εξέταση αίματος θα ανιχνεύει τον καρκίνο του μαστού έως και πέντε χρόνια πριν από τα συμπτώματα
Τα ποσοστά επιβίωσης εκτοξεύονται όταν γίνεται έγκαιρη διάγνωση. Αυτή η είδηση μας φέρνει πιο κοντά στη νίκη της νόσου.
Η καθημερινή υπερτροφή που θωρακίζει οστά και ανοσοποιητικό. Πότε κρύβει κίνδυνο πρόωρου θανάτου
Ποιος είναι ο καλύτερος τρόπος να την καταναλώσετε, τι πρέπει να αποφύγετε για να προστατευτείτε.
Άρχισα να πίνω καθημερινά γάλα καρύδας και ιδού τα οφέλη στο σώμα μου
Με κρεμώδη υφή και ελαφρά φυσική γλυκύτητα, το γάλα καρύδας συχνά θεωρείται ως «υγρό θαύμα».
Ο καταξιωμένος γιατρός που θα νικήσει την παιδική λευχαιμία με ένα γιαούρτι
«Εδώ και τριάντα χρόνια αναζητώ εμμονικά τους λόγους της παιδικής λευχαιμίας. Τώρα επιτέλους έχουμε μια απάντηση» δήλωσε ο Βρετανός επιστήμονας Mel Greaves.